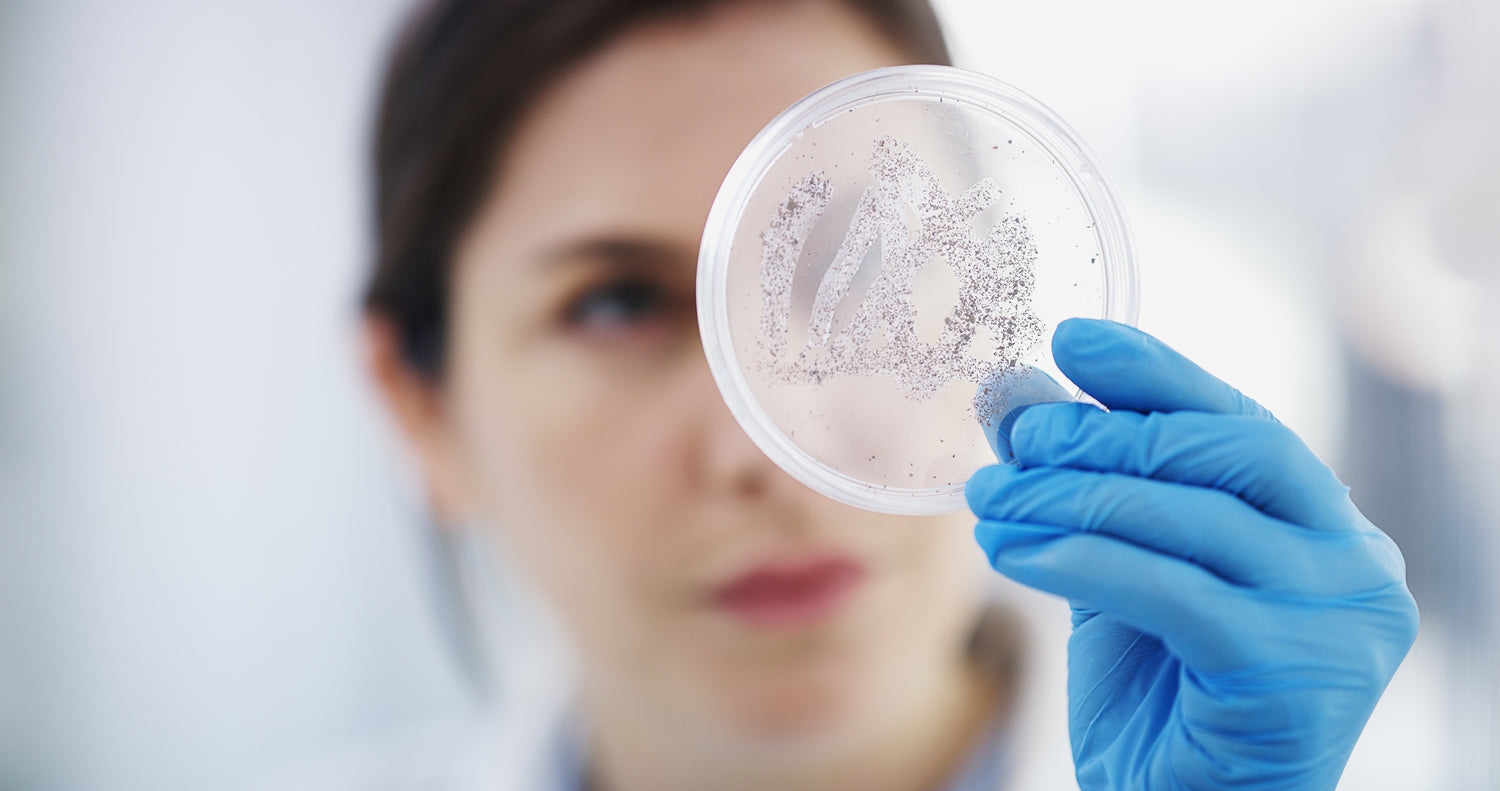
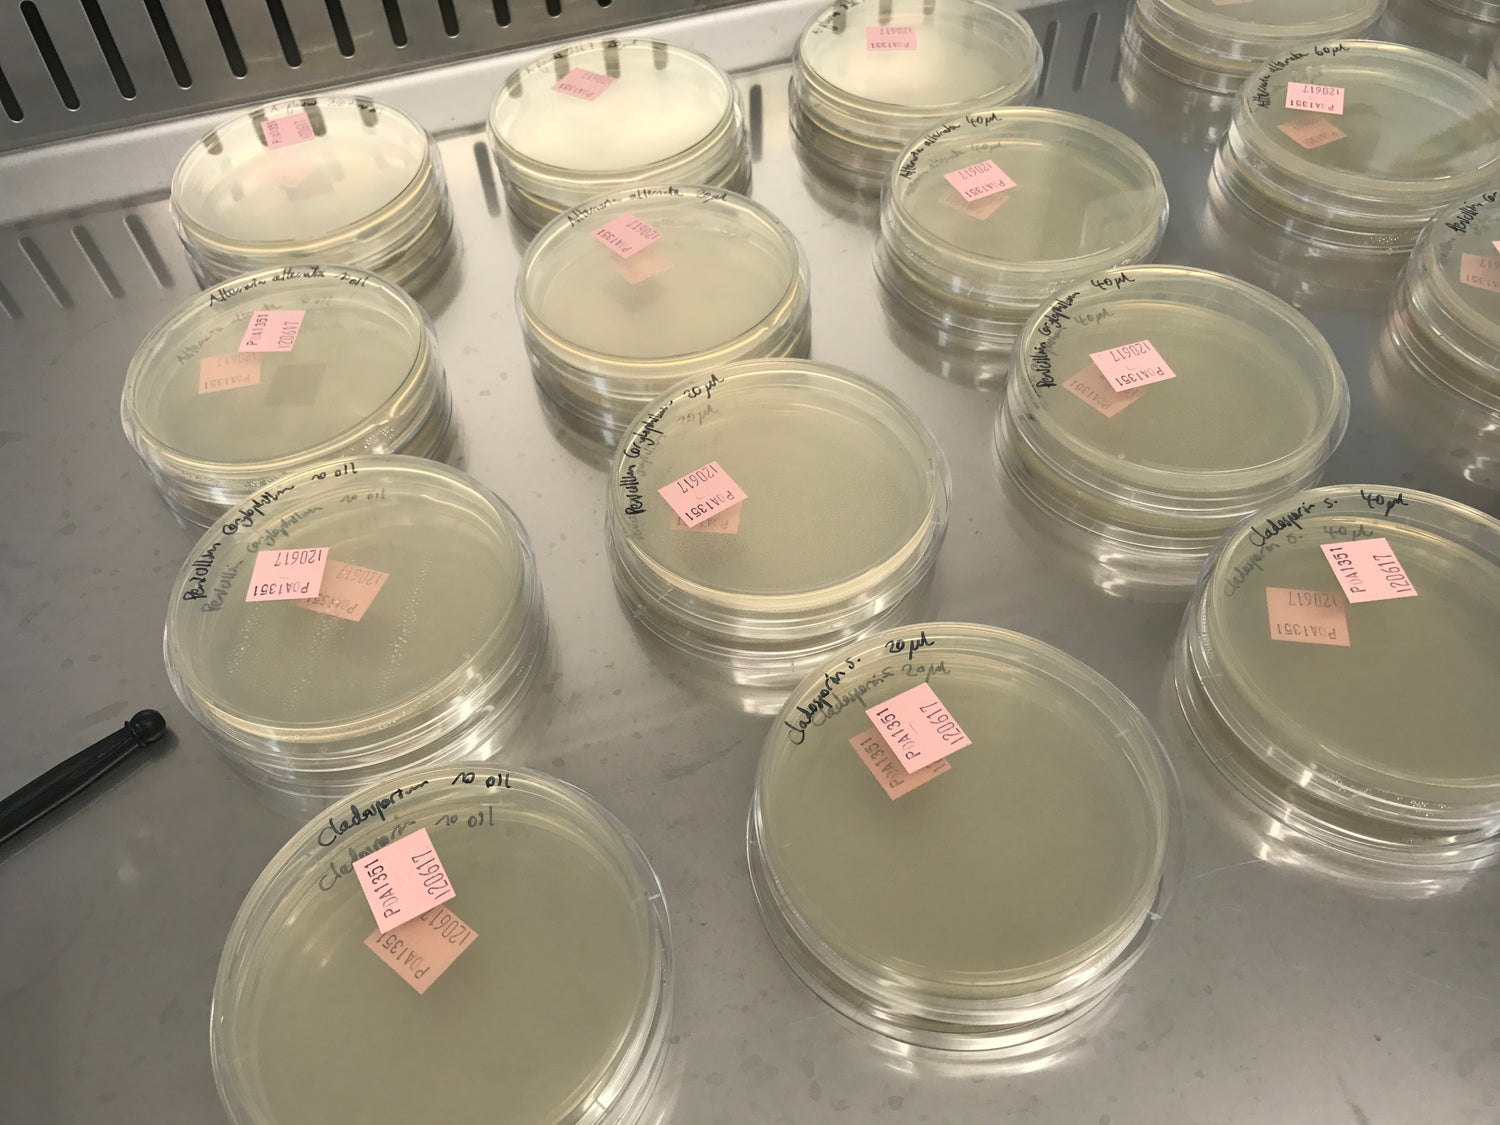
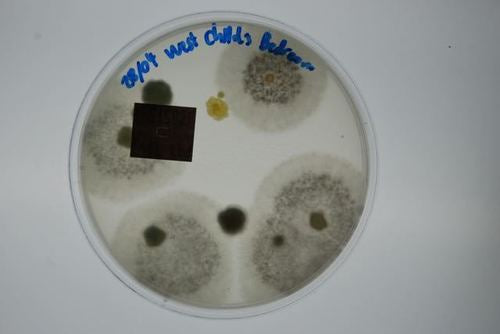
2-Sample Mould Test Kit
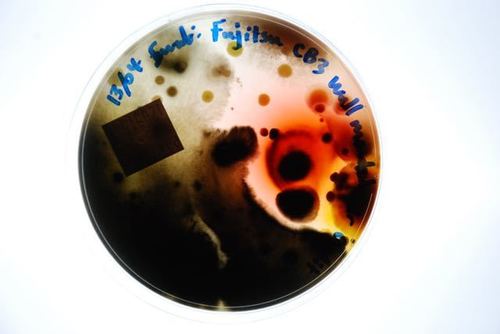
4-Sample Mould Test Kit

Certified Company Technically Competent For Laboratory Testing
We are an ISO9001:2015 Certified Company and have been assessed and comply with the requirements of ISO 17025:2017 General requirements of testing laboratories while demonstrating technical competence in the field of testing laboratories for quality and competence.
When in doubt - get it tested
Find out what a DIY mould test kit can do for you
Is Your Home Making You Sick?
Easily work out if your home or office is contaminated? This allows you to make decisions based on facts or help prove your claims to other persons
This test is an efficient way to identify harmful pathogens you and your family may be inhaling on a regular basis. Prolonged exposure to mold may lead to severe health effects, making the correct mold testing solution imperative.
Health-Related Warning Signs of Mould
Mould.net.au has developed a cutting-edge DIY mould test kit to identify airborne toxic mould throughout your home or office. We have pioneered a unique approach that potentially eliminates the need for an occupational hygienist, independent environmental professional or building biologist to attend to collect the samples. Our DIY test kits are an affordable first step in determining if a full inspection is required. This test is an efficient way to identify harmful pathogens you and your family may be inhaling or touching on a regular basis. Prolonged exposure to mould may lead to severe health effects, making the correct mould testing solution imperative.